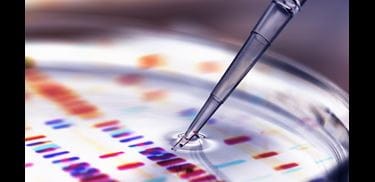
Glass.Mapper.Sc.Fields.Image?.Alt

- 在此页面上
我们的生命科学和医疗保健团队与世界上一些最大的制药、生物技术和医疗设备公司和医疗保健提供商、准备扩大业务规模的各种中小型初创企业以及介于两者之间的许多公司合作。在这些充满活力和创新的行业中,我们引导雄心勃勃的全球客户应对错综复杂的法律、商业和监管挑战。
我们通过战略合作伙伴合作、融资或配资或完成改变游戏规则的并购交易,为生命科学和医疗保健客户设计具有变革意义的商业交易,并处理专利诉讼、产品责任和与监管机构的纠纷等争议事项。
我们的生命科学和医疗保健团队通过就客户复杂的监管、竞争、合规和数据保护要求提供实用的商业建议,保护客户业务的价值,实现全球扩张。
无论我们的客户是制药、生物技术、医疗设备(包括IVD)、数字医疗还是医疗保健行业,公司和投资者都非常重视我们在欧洲、中东和亚洲提供无缝法律和监管建议的能力。通过与我们的合作伙伴网络合作,我们可以确保全球覆盖,包括关键的美国市场。
经验
Advising gene therapy company AlveoGene on its complex spinout and launch investment
We have advised AlveoGene, a new UK gene therapy company on its complex spinout from the Gene Therapy Consortium of Imperial College and the Universities of Oxford and Edinburgh focusing on rare respiratory diseases, as well as on its seed round investment.
Press releaseApollo Therapeutics closes $226.5 million series C financing
We advised Apollo Therapeutics in their USD226.5 million series C fundraising. Apollo aims to advance pipeline programs through clinical development and further fund the company’s drug discovery and development activities based on breakthroughs in basic medical research made at its partner institutions, which include The Institute of Cancer Research.
Press releaseSuccessful financing and add on acquisitions for Oberberg Group
Oberberg Group on the successful refinancing of its existing credit lines. The new financing also served several add-on acquisitions. This included the internationally renowned private clinic Jägerwinkel am Tegernsee, which is expanding the treatment spectrum of the Group with its range of integrative holistic psychosomatics with a focus on interdisciplinary pain therapy. In addition, Panorama Fachklinik, an acute hospital for psychosomatics, and Privatklinik Hubertus im Allgäu, a specialist hospital for psychosomatics, psychotherapy and naturopathy, were acquired.
Press releaseBabylon Health continues to invest in digital healthcare with largest European and US fundraising
Babylon Health, a UK-based digital health subscription provider, on its USD550m fundraising to support expansion into the US and Asia. This is the largest ever fundraising in the European or US digital health sector and values Babylon at over USD2bn. Investors included PIF, ERGO Fund, Kinnevik and Vostok New Ventures.
Press releaseSteadfast Capital Fund IV on the acquisition of a majority stake in Söhngen Group
Steadfast Capital Fund IV on the acquisition of a majority stake in Söhngen Group. The transaction included both W. Söhngen GmbH based in Taunusstein (Hesse) and Silva GmbH based in Mainhausen (Hesse). The parties have agreed not to disclose the purchase price. The majority acquisition aims to support further growth of the Söhngen Group with its internationally recognised brands and premium products in the market for first aid and emergency medical products both organically and through acquisitions. We also advised on the financing of the acquisition.
Press releaseNORD Holding on the acquisition of Zentrum Gesundheit Group
NORD Holding, a leading private equity house, on the acquisition of the majority interest in Zentrum Gesundheit Group, a leading German group of ophthalmic surgery and diagnostic centres, from Waterland Private Equity. NORD Holding, together with the management and medical team, acquired a stake as a new partner and majority shareholder. In this deal the Taylor Wessing team again demonstrated its interdisciplinary expertise in the areas of healthcare M&A, regulatory and acquisition financing.
Press release最新新闻和观点
Carve-outs – Life sciences investment opportunities in a recovering M&A market

Regional Court of Bochum: Request for a preliminary ruling to the CJEU – Are blank patient wristbands for hospital use considered medical devices?

Federal Court of Justice: "Gentle on the skin" is misleading advertising for biocidal products
我们的团队
工具和在线服务










